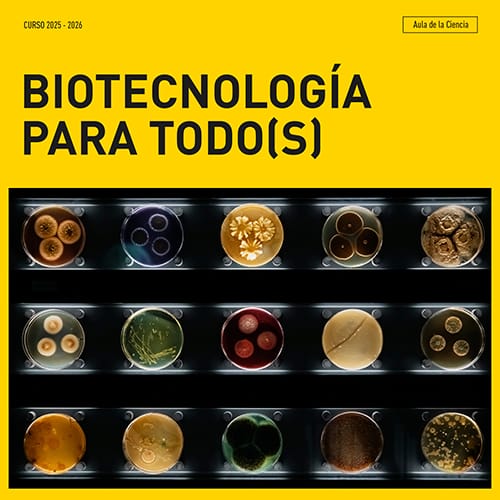
Biotecnología para todo(s): El ADN del viñedo: lo que el microbioma nos cuenta

Charla sobre cómo la biotecnología y la genómica permiten identificar microorganismos en el viñedo y su impacto en la viticultura.
Este jueves 12 de febrero, el Paraninfo de la Universidad de Cantabria en Santander abre sus puertas para una charla que une la ciencia de vanguardia con una de las tradiciones más antiguas de nuestra tierra: el cultivo de la vid. A partir de las 20:00h, la investigadora María de Toro Hernando estará al frente de la sesión titulada Biotecnología para todo(s): El ADN del viñedo: lo que el microbioma nos cuenta. El objetivo es explicar cómo la genómica y las herramientas biotecnológicas actuales están permitiendo descubrir un mundo que hasta hace poco era totalmente invisible para los viticultores. No se trata de una charla técnica cerrada a especialistas, sino de un encuentro pensado para el público general que tenga curiosidad por saber qué ocurre realmente bajo el suelo de los viñedos.
Cada semana elegimos 🏆 los 5 mejores 🏆 planes de Santander y te los enviamos. Solo un email semanal, sin spam.
Al enviar tu correo, aceptas nuestra Política de Privacidad
El núcleo de la exposición de María se centra en el uso de las técnicas de secuenciación masiva, conocidas como NGS. Gracias a estos avances, ahora es posible identificar miles de microorganismos, como bacterias, hongos y levaduras, sin necesidad de pasar por los procesos tradicionales de cultivo en laboratorio. Esta biodiversidad invisible es la que realmente define el carácter de un viñedo. Durante la charla se analizará cómo elementos externos como el clima, la composición del suelo y las prácticas agrícolas diarias modifican este microbioma. Es una perspectiva diferente para entender el concepto de terroir y cómo la biotecnología puede ayudar a que la viticultura sea más precisa y, sobre todo, más respetuosa con el medio ambiente al entender mejor los procesos naturales que ya ocurren en la tierra.
Para asistir a este evento en el Paraninfo, la entrada es gratuita hasta que se llene el espacio. Sin embargo, para evitar sorpresas de última hora, se ha habilitado la posibilidad de realizar una reserva previa a través de la web meapunto.unican.es. Esta cita forma parte del ciclo Biotecnología para todo(s), una iniciativa que busca acercar la ciencia cotidiana a los vecinos de Santander de una forma relajada. Es una oportunidad para conocer de cerca cómo la genómica está abriendo una nueva era en la agricultura, conectando la biodiversidad microscópica con la sostenibilidad de los campos, permitiendo que la tecnología trabaje a favor de la naturaleza y no en su contra.
Fecha
jueves, 12 de febrero de 2026
20:00
Precio
Gratis
Edad Recomendada
+16 años











Cada semana elegimos 🏆 los 5 mejores 🏆 planes de Santander y te los enviamos. Solo un email semanal, sin spam.
Al enviar tu correo, aceptas nuestra Política de Privacidad